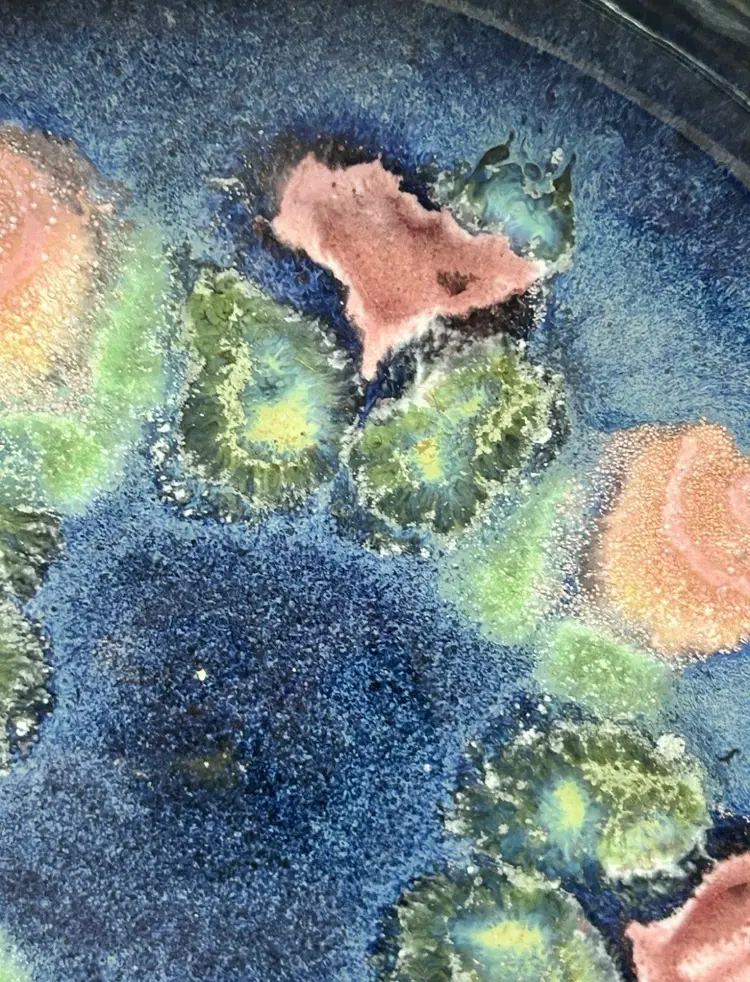
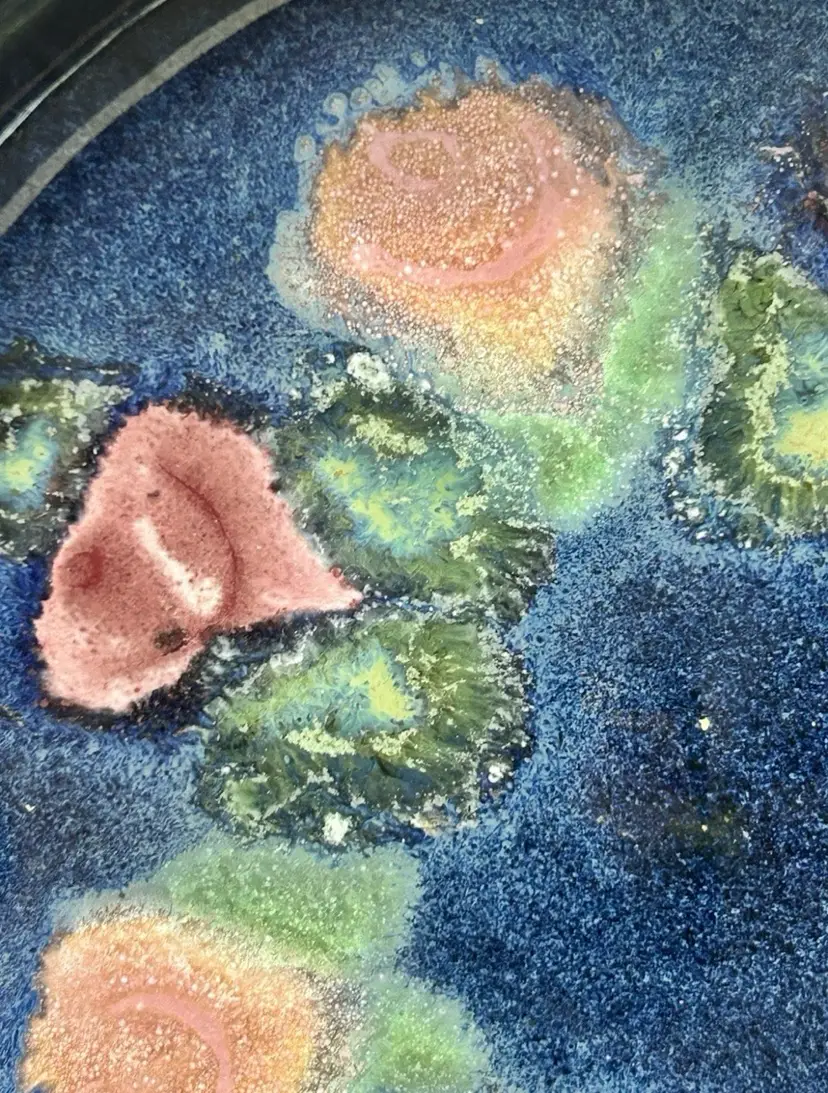

VTG Susan Demay Stoneware Pottery Navy Blue Floral Bouquet Serving Bowl Signed
Details
The Vintage Susan Demay Stoneware Pottery Navy Blue Floral Bouquet Serving Bowl is a beautifully crafted piece of art pottery from America. Handmade with a glossy finish, this round bowl features a stunning bouquet pattern in a multicolor design of greens and pinks, making it a perfect decorative piece for various occasions such as birthdays, anniversaries, and more. With its vintage style and contemporary design, this bowl is a unique and eye-catching addition to any home decor collection and it has been signed by the artist Susan DeMay. Vintage Susan Demay Stoneware Pottery Navy Blue Floral Bouquet Serving Bowl Signed is in excellent vintage "like new" condition, with NO chips, cracks or repairs. However, it does show slight wear consistent with its vintage pre-owned condition.
37 Views
Meet Your Seller
Selling since February 2024
Cani's Corner Vintage and More came about quite unexpectedly. After a big move from Southern New Jersey to Springfield, Tennessee, I started visiting local antique stores and attending estate sales in attempt to learn more about my new city and state. In the process, I fell in love with finding beautiful vintage treasures and their history. And now, I have the pleasure of presenting them to you here. I hope that you find the items listed just as interesting and beautiful as I do. Feel free to follow, share with your friends and family, and shop to your heart's content. Thanks for visiting and see you around the corner. ~Cani
Report Listing
Report Listing